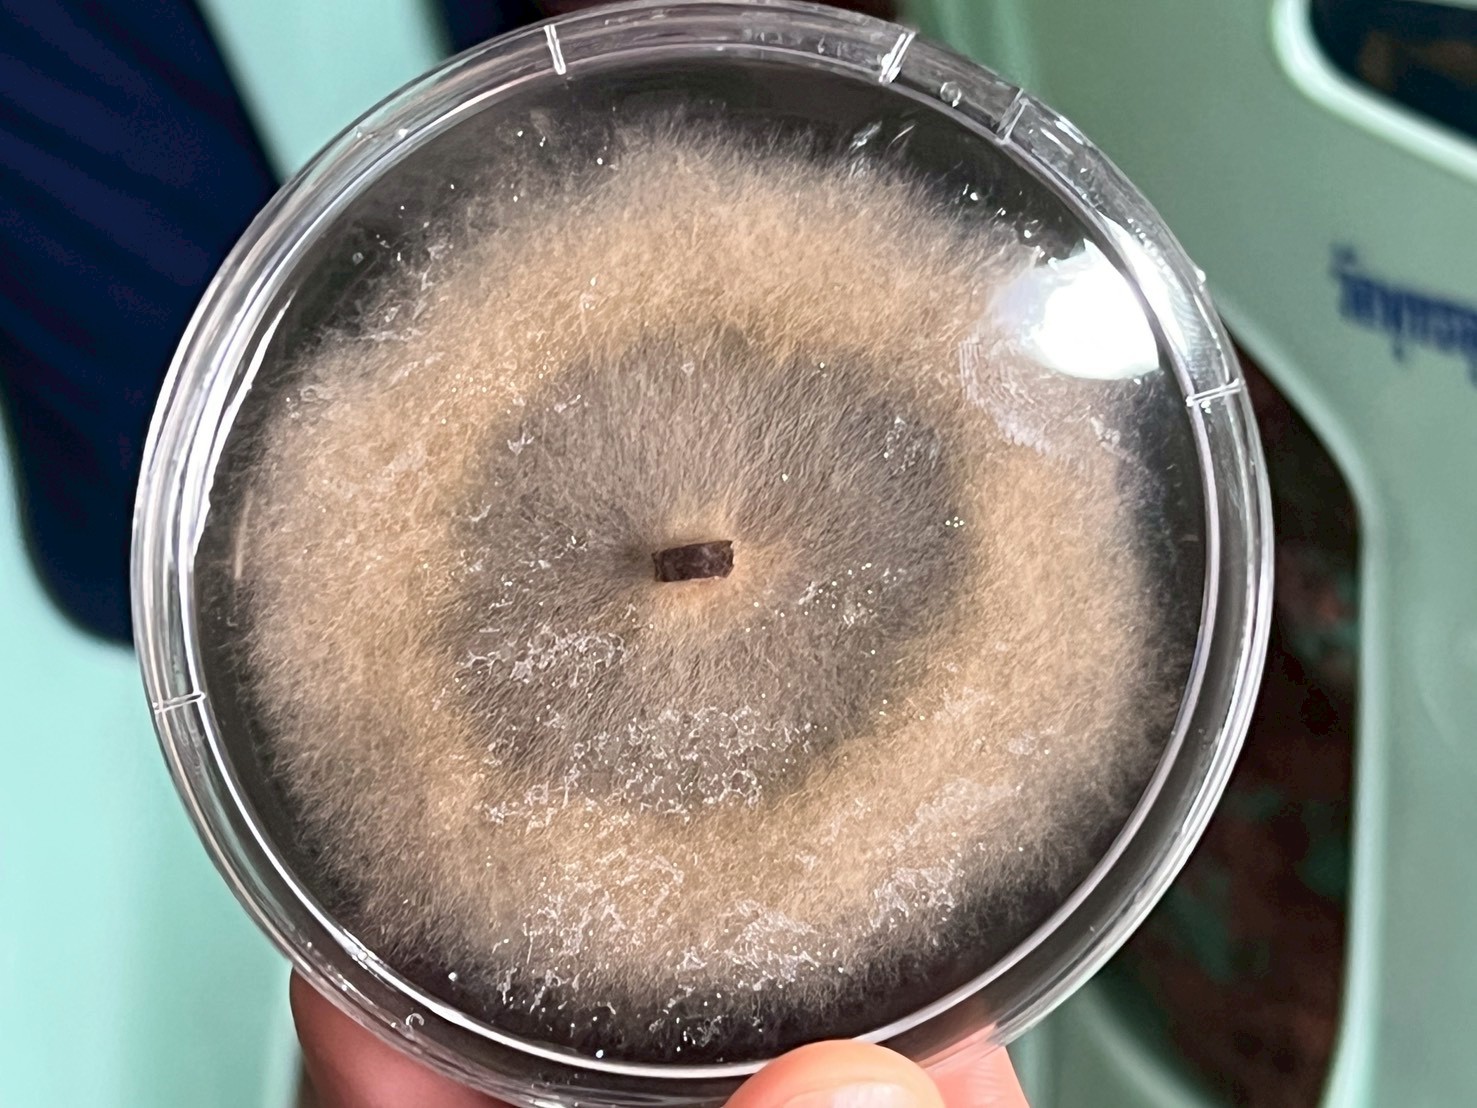

วันที่ 24 กันยายน 2568 เวลา 08.30 น. นางพรรณี สุขใส ผู้อำนวยการศูนย์ส่งเสริมและพัฒนาอาชีพการเกษตรจังหวัดเชียงราย มอบหมายให้เจ้าหน้าที่ศูนย์ฯ เข้าร่วมอบรมเชิงบรรยายและปฏิบัติการโครงการวิจัย ” การใช้เห็ดป่าไมคอร์ไรซาเพื่อแก้ปัญหาไฟป่าหมอกควันอย่างยั่งยืน ” ภายใต้แผนงาน “ประเทศไทยปลอดภัยจาก PM 2.5 เพื่อสร้างการรับรู้ความเข้าใจที่ถูกต้องเกี่ยวกับเห็ดไมเคอร์ซา และแรงผลักดันที่จะทำให้คนหันมาปลูกไม้ป่าที่เป็นพืชอาศัยของเห็ดไมเคอร์ไรซาเพื่อเป็นอาหารและรายได้เสริมในพื้นที่ของตนเองมากขึ้น ซึ่งเป็นแนวทางหนึ่งที่ทำให้ไฟป่าและหมอกควันจากการเผาป่าของชาวบ้านในพื้นที่อุทยานแห่งชาติ ป่าสงวน ป่าชุมชนลดลง และจะเป็นต้นแบบในการบริหารจัดการไฟป่าและการใช้ทรัพยากรธรรมชาติจากป่าอย่างยั่งยืน โดยมีผู้ช่วยศาสตราจารย์ ดร.จิตรตรา เพียภูเขียว เป็นประธานกล่าวเปิดกิจกรรมฯ ณ ศาลารวมพลังแผ่นดิน วัดพุทธอุทยานดอยอินทรีย์ ตำบลดอยฮาง อำเภอเมือง จังหวัดเชียงราย
ศสพ.ชร. ร่วมอบรมเชิงบรรยายและปฏิบัติการโครงการวิจัย ” การใช้เห็ดป่าไมคอร์ไรซาเพื่อแก้ปัญหาไฟป่าหมอกควันอย่างยั่งยืน “